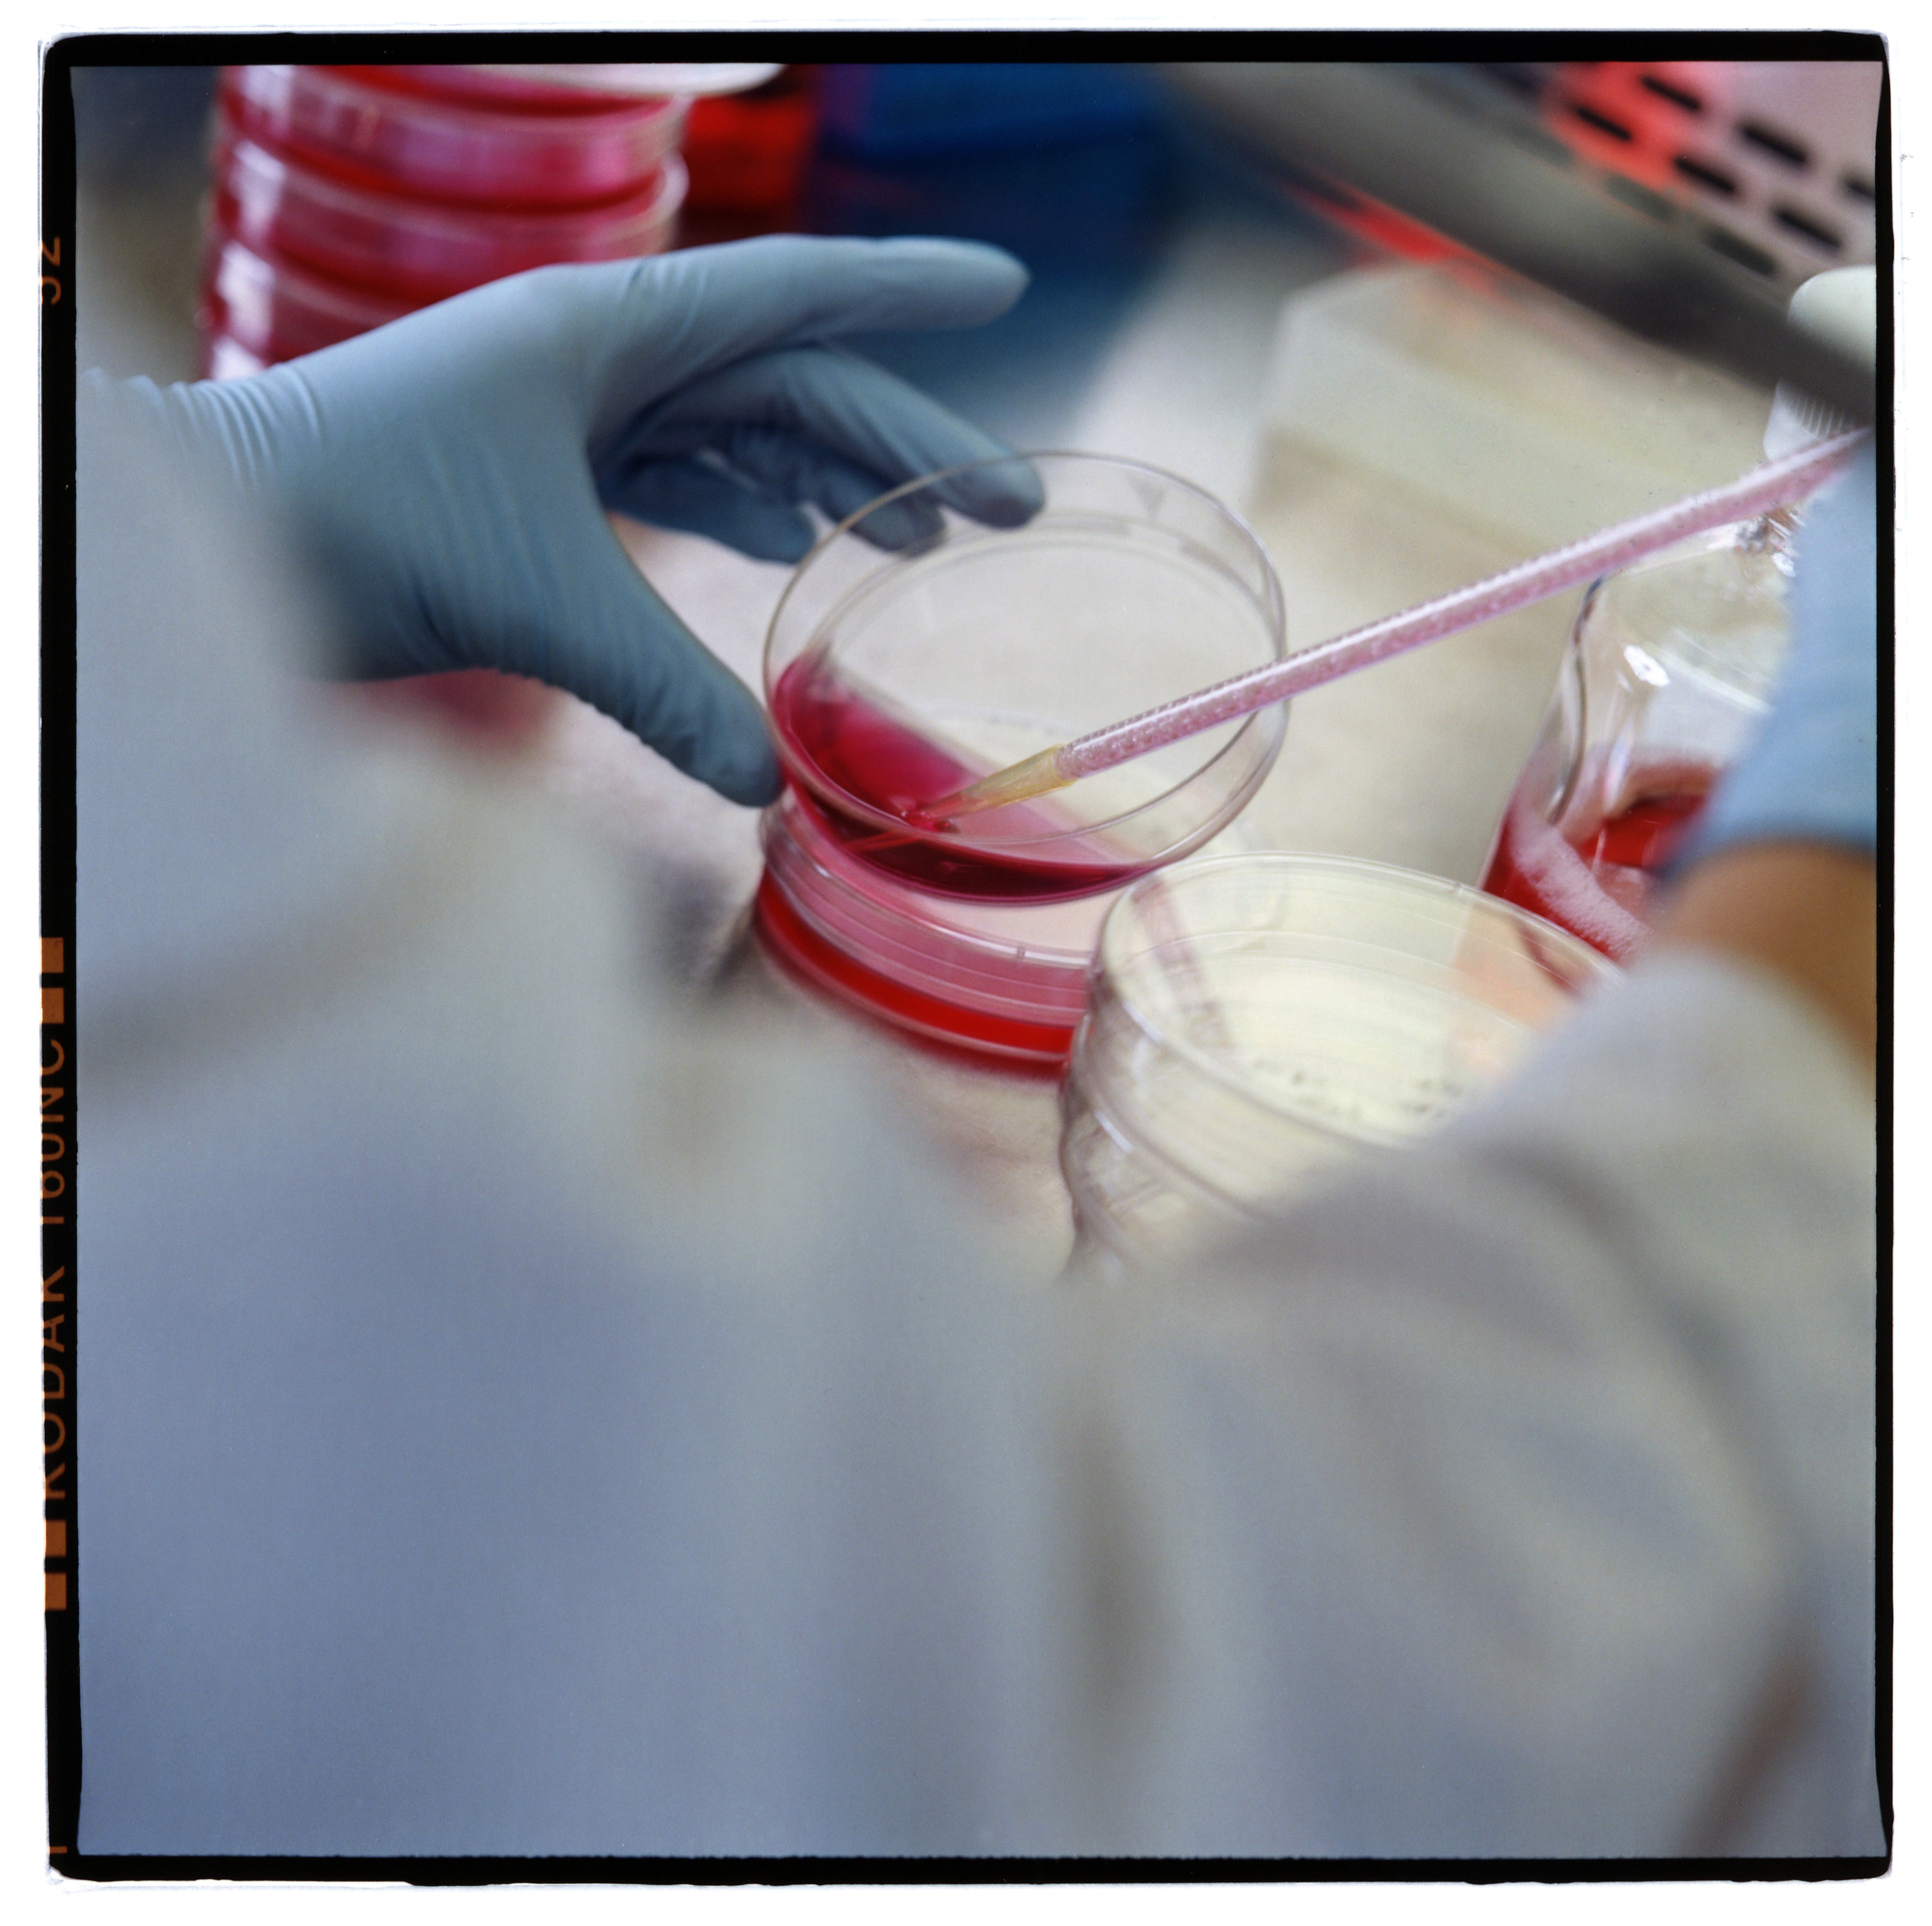

Долгая дорога лекарств к пациенту
Путь медикамента от момента его создания до выхода на рынок лекарственных средств не только крайне длителен - иногда он занимает до 30 лет – но и наполнен многочисленными препятствиями. А с прошлого года, по словам представителей фармакологической индустрии и создателей медикаментов, он стал еще более сложным.
Органы здравоохранения проявляют теперь еще большую осторожность и требуют дополнительную документацию, говорит Штефан Фрингс (Stefan Frings), директор по медицинским вопросам в фармацевтической компании «Roche» в Базеле.
Несколько десятилетий назад противораковые медикаменты можно было свободно коммерциализировать. Сегодня на рынке оказываются только те лекарства против различных видов рака, которые прошли научные испытания, пояснил Ш. Фрингс для swissinfo.ch. Тем самым власти хотят убедиться, что новые лекарства надежны и по эффективности превосходят уже существующие методы медикаментозного лечения.
Только один из 5 000 препаратов-кандидатов соответствует всем требованиям и бывает одобрен для продаж.
250 медикаментов из 5 000-10 000 препаратов доходят до того момента, когда их начинают тестировать на животных. Около 10 из них допускаются к клиническим испытаниям.
По данным Центра Тафтса по изучению и разработке лекарств (Tufts Center for the Study of Drug Development), зарегистрированного в Бостоне, только два препарата из десяти окончательного утверждаются и выпускаются на рынок.
Важнейший критерий – цена
Получить разрешение на выпуск медикамента со стороны Швейцарского ведомства лекарств («Swissmedic») или от регулирующих органов Европы и США – лишь одно из многих препятствий, которые нужно преодолеть. Фирмы-производители должны договориться о ценах на лекарства с властными структурами, которые определяют размер компенсации за медикаменты со стороны компаний медицинского страхования. В Швейцарии за это отвечает министерство здравоохранения.
Для швейцарского правительства медикамент считается экономически эффективным, когда он достигает желаемого результата при минимально возможной цене. Экономическая эффективность лекарства, по словам спикера министерства здравоохранения Даниэля Даувальдера (Daniel Dauwalder), оценивается по сравнению с другими видами лечения и с ценой этого препарата в других странах.

Показать больше
Рак и бизнес
Низкая статистическая вероятность
Вероятность, что медикамент сумеет преодолеть все препятствия на пути из лаборатории к практическому применению, чрезвычайно низка. Она составляет 1:5000. Такие цифры приводит независимый некоммерческий научно-исследовательский Центр Тафтса по изучению и разработке лекарств (Tufts Center for the Study of Drug Development) при Университете Бостона. Расходы, связанные с созданием одного-единственного лекарства, от начала до конца, равняются порядка 1,9 миллиарда франков, говорится в опубликованном в 2006 году исследовании о расходах в сфере здравоохранения.
Первый шаг в разработке нового лекарства от рака – это ответ на вопрос, что делает рак с человеческим телом. «Чем лучше мы понимаем болезнь, тем эффективнее можем изучить пациента и прописать ему лечение», — говорит Ш. Фрингс.
«Некоторые молекулы и на ранних этапах исследований показывали себя многообещающими. К примеру, с веществом «Зельбораф» («Zelboraf») мы знали уже во время первой фазы, что сможем создать на его базе лекарство. В этом уникальном случае понадобилось пять лет, чтобы получить разрешение на его коммерциализацию у властей США». «Зельбораф» используется в США и Европе как лекарство при некоторых видах меланомы.
Среди ученых, занимающихся в Швейцарии исследованиями в области борьбы с раком, есть и две наших соотечественницы. Выпускница химфака МГУ, профессор Татьяна Петрова, живет в Лозанне. Она возглавляет научную лабораторию «CePO UNIL – CHUV» («Междисциплинарного онкологического центра Университета Лозанны и Университетской клиники кантона Во»).
В Швейцарию Татьяна Петрова приехала в 1996 году, чтобы защитить здесь диссертацию. Затем она несколько лет проработала в США и Финляндии, а в 2008 году вернулась в Швейцарию, где создала собственную научную группу, которая занимается исследованиями лимфатических сосудов и их ролью в развитии раковых заболеваний.
В феврале 2013 года Татьяна Петрова и ее коллега, профессор Амели Сабин, вошли в число девяти лауреатов премии фармацевтической компании «Pfizer» за совместную работу под названием «Новые знания о формировании и работе лимфатических узлов».
«После рака груди и удаления лимфатических узлов множество пациенток страдают от лимфедемы, хронического скапливания лимфатической жидкости. Исследование соответствующих молекулярных процессов исключительно важно для предупреждения и терапии лимфедемы», — пояснили исследовательницы.
Еще одним лауреатом премии «Pfizer» в категории «Онкология» стала кандидат наук Ольга Шахова из Университета Цюриха. Ее наградили за определение гена, играющего центральную роль в развитии меланомы. Ольга Шахова тоже училась в МГУ, на факультете биологии. В 1998 году она приехала в Цюрих, чтобы защитить диссертацию, и с тех пор продолжает свои исследования здесь, в «Институте биохимии Университета Цюрих». В 2005-2006 гг. она работала в Лондоне.
О. Шахова входит в научную группу профессора Лукаса Зоммера (Lukas Sommer), занимающейся исследованиями меланомы — рака кожи. Это болезнь коварна тем, что первичную опухоль можно просто не заметить, ведь ее размеры могут не превышать нескольких миллиметров. Поэтому часто больные обращаются к врачу, когда уже слишком поздно.
Заболевания меланомой находятся сегодня на первом месте по доле летальных исходов среди всех видов раковых болезней. Препараты, использующиеся в терапии меланомы, помогают только вначале, а уже через несколько недель меланома приспосабливается к ним и развивается дальше.
«Мы обнаружили ген, — он называется «SOX10», — который нужно «отключать», — пояснила Ольга Шахова порталу swissinfo по телефону. У больных меланомой он слишком активен. Необходимо создать лекарство, которое дезактивировало бы ген и тем самым прервало программу размножения раковых клеток. Это вполне реализуемый проект».
«В мае этого года я планирую обратиться в «Швейцарский национальный научный фонд» (SNF) с тем, чтобы представить мою программу создания собственной научной группы», — рассказала Ольга Шахова. «Группа будет заниматься исследованием рака, которые поражает детей — нейробластомы. Нас поддерживают в этом «Детская больница Цюриха» («Kinderspital») и «Цюрихская университетская клиника.
Детский рак очень агрессивен. Я уже работала в Лондоне с еще одним видом детского рака, медуллобластомой. Это злокачественная опухоль мозжечка, которая развивается у очень маленьких детей, ее стараются оперировать на ранних стадиях, что дает какой-то, пусть очень небольшой, процент излечений. Нейробластома – самый мифический из видов рака. Он появляется у детей до одного года, а затем либо метастазируется, либо исчезает. До сих пор врачи не понимают, почему? На мой взгляд, изучить механизм нейробластомы – это идеальный способ понять функционирование всех видов рака».
Премия «Pfizer» за научную работу – одна из наиболее престижных в области медицинских исследований. Она вручается молодым ученым, которые работают в научно-исследовательских центрах и клиниках Швейцарии и вносят важный вклад в продвижение фундаментальных и клинических исследований. Всего ее получили уже 237 ученых, общая сумма вознаграждения составила 5,2 миллиона франков. Девять лауреатов этого года поделили между собой 105 тысяч франков.
Долгий путь лекарства к пациенту
Тридцатилетний период до выхода медикамента в продажу – вполне нормальная практика, в среднем же этот этап длится не менее 10 лет. «Перьета» («Perjeta»), новейший препарат против рака груди от компании «Roches», в Европе был допущен на рынок за несколько недель – и это после четверти века фундаментальных научных исследований, сделавших возможными его открытие.
«Фармацевтическая компания должна быть в состоянии просуществовать 10-20 лет, не прекращая свои исследования. Если она не может этого сделать, то рано или поздно будет вынуждена покинуть рынок», — говорит Ш. Фрингс.
Множество успешно действующих лекарств от рака стали результатом фундаментальных исследований в университетах и научных центрах. В Швейцарии эти проекты, главным образом, финансируются «Швейцарской лигой исследований раковых заболеваний» и «Швейцарским национальным научным фондом».
Последний является одним из наиболее важных в Швейцарии институтов фундаментальных научных исследований. С 2008 по 2012 годы он выделил 1000 миллионов франков на раковые исследования. В ближайшие годы эти суммы еще вырастут, говорит спикер «Швейцарского национального научного фонда» Ори Шиппер (Ori Schipper).
Несколько фаз разработки
Результаты фундаментальных исследований часто используются в процессе разработки лекарств намного позже, когда становится ясно, какую роль они играют в истории болезни. «Некоторые открытия, сделанные еще в1990-х годах, по-прежнему помогают при разработке новых лекарств», — рассказывает Ш. Фрингс.
Поэтому само по себе научное открытие является лишь первым шагом. Небольшие биотехнологические компании проверяют потенциальные препараты-кандидаты, потом тестируют молекулы. Позже лекарства, которые еще не сошли с дистанции, продают крупным фармацевтическим компаниям, таким как «Roche» и «Novartis».
Ученые, разработчики медикаментов, тестируют новые химические вещества в лаборатории и затем на человеке. Они сначала проверяют их безопасность и только потом эффективность. В третьей фазе процесса новый препарат сравнивают с уже существующей терапией. На заключительном этапе препараты должны быть одобрены властями.
Высокие требования
Нормативные требования касаются не только разработчиков лекарств, но и научно-исследовательских учреждений, которые осуществляют клинические испытания. По данным Швейцарского общества клинических исследований рака (Schweizerische Gesellschaft für klinische Krebsforschung, SAKK), количество разрешений на новые препараты сократилось с 2005 по 2011 год на 40%.
«Причиной такого снижения является чрезмерное регулирование. Это делает Швейцарию непривлекательной, поскольку процессы, во-первых, стоят дорого, а во-вторых, идут медленно»,- говорит президент SAKK Беат Тюрлиманн (Beat Thürlimann).
По словам пресс-секретаря Швейцарского ведомства лекарств Даниэля Люти (Daniel Lüthi), принципы, по которым оценивают лекарства, не изменяются. Люти допускает, однако, что научно-технические знания значительно возросли в последние 20 лет, и вместе с ними и нормативные требования».
Для онколога Тюрлимана развитие новых лечений рака важно как никогда. В Швейцарии каждый год регистрируется 40 000 новых случаев заболевания раком. А умирает от этой болезни в Швейцарии, по данным Лиги рака, 16 000 человек ежегодно.
Перевод с немецкого и адаптация: Людмила Клот, Надежда Капоне

В соответствии со стандартами JTI
Показать больше: Сертификат по нормам JTI для портала SWI swissinfo.ch




















Обзор текущих дебатов с нашими журналистами можно найти здесь. Пожалуйста, присоединяйтесь к нам!
Если вы хотите начать разговор на тему, поднятую в этой статье, или хотите сообщить о фактических ошибках, напишите нам по адресу russian@swissinfo.ch.